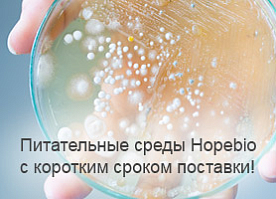
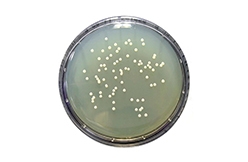

Подпишись на рассылку и выиграй телефон!

Биотех
Компания «МИЛЛАБ» обеспечивает поставку оборудования и расходных материалов для лабораторий микробиологии и производственных площадок на фармацевтических предприятиях.
Преимущества НАПРАВЛЕНИЯ
УДОБСТВО
Склад в Москве с запасом востребованного оборудования
КАЧЕСТВО
Официальный дистрибьютор ведущих мировых производителей
ГАРАНТИЯ
Сервисная поддержка всего оборудования
ПРОФЕССИОНАЛИЗМ
Комплексные поставки, реализация технически сложных проектов
Оборудование
Решения
Партнеры
Новости
Подпишись на рассылку и выиграй телефон!

Аналитика
 Аналитическое и научное оборудование
Аналитическое и научное оборудование
Общелабораторное оборудование
Лабораторная мебель
Общелабораторное оборудование
Лабораторная мебель
Биотех
 Оборудование для микробиологии и фармацевтики
Оборудование для микробиологии и фармацевтики
Расходные материалы
Питательные среды
Расходные материалы
Питательные среды
Биотех
Синтез
 Оборудование для лабораторного, пилотного и крупнотоннажного синтеза
Оборудование для лабораторного, пилотного и крупнотоннажного синтеза
Технология
 Испытание материалов
Испытание материалов
Термообработка
Вакуумное оборудование
Термообработка
Вакуумное оборудование
Инжиниринг
 Проектные решения для производства и лабораторий.
Проектные решения для производства и лабораторий.
Предпроект, 3D- визуализация.
Предпроект, 3D- визуализация.
Сервис
 Сервисная поддержка
Сервисная поддержка
Аттестация, валидация оборудования
Поставка запасных частей
Аттестация, валидация оборудования
Поставка запасных частей
Контакты
© 1996 - 2025 компания «Миллаб»















































































































































.jpg)